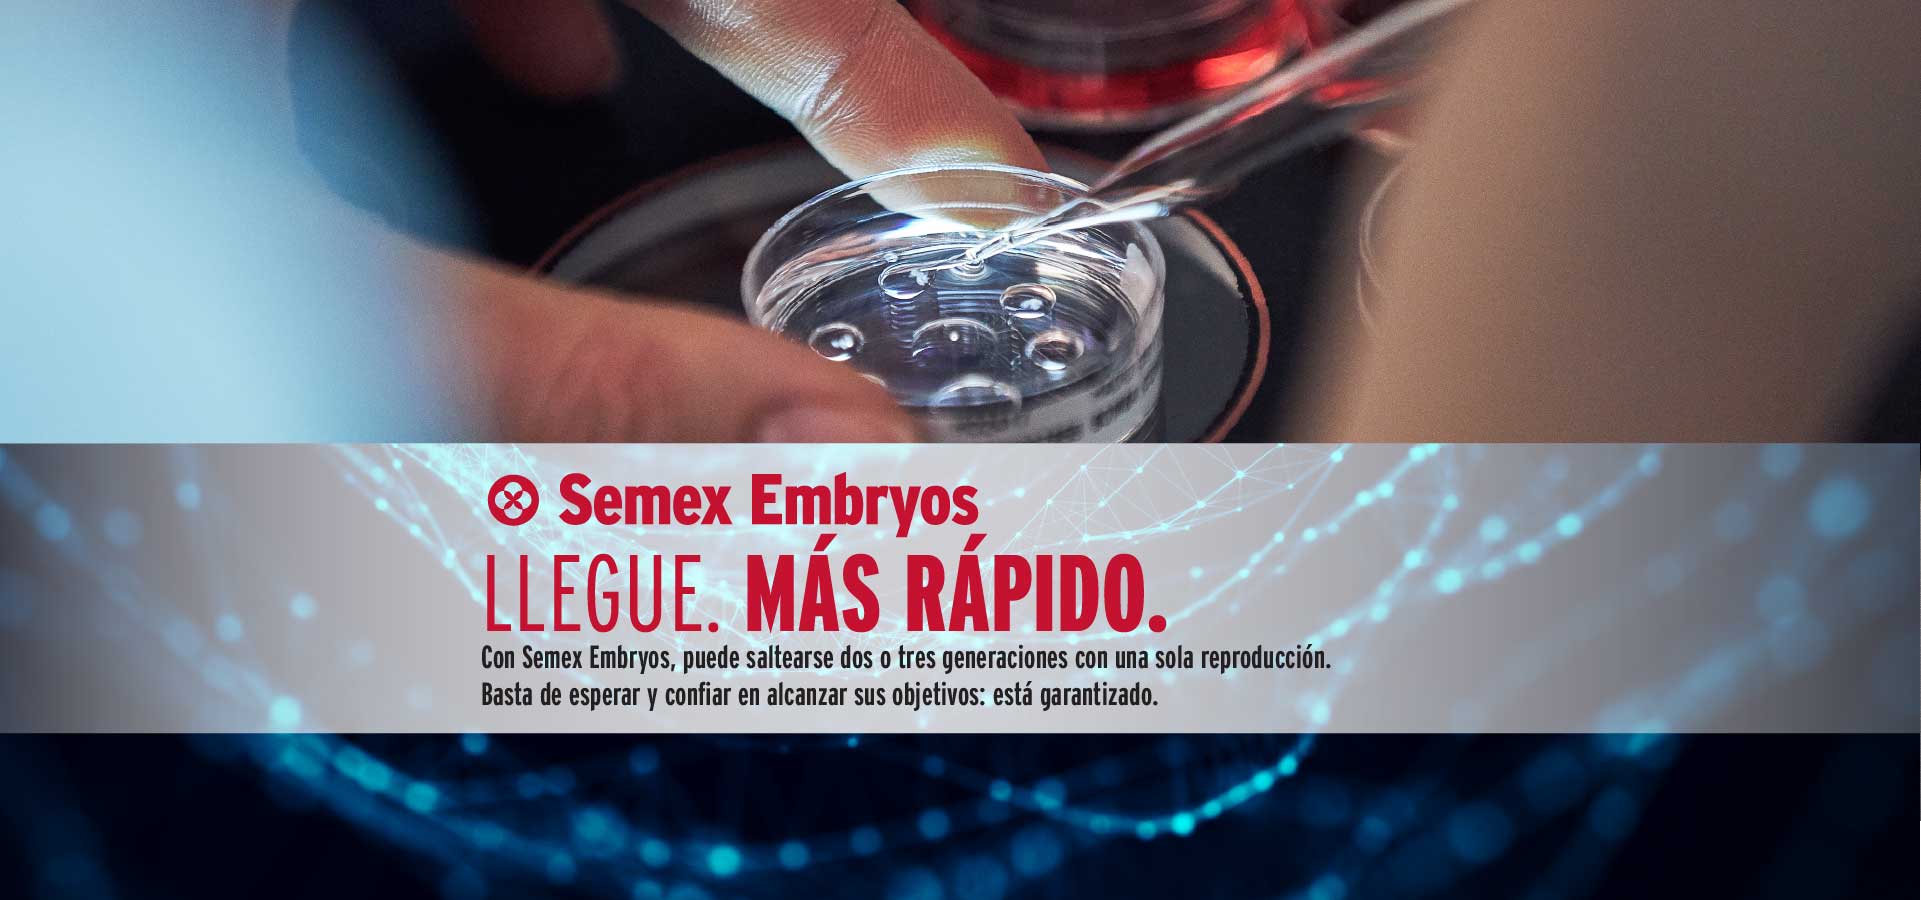
Embryosweb_bannersSP-01.jpg

Enfocando la fertilidad, la salud y la longevidad para construir un rebaño rentable
La única empresa que ofrece genética inmunológica para mayor resistencia a la enfermedad.
Brindando los sementales más codiciados y rentables del mundo.
Menos nacimientos problemáticos hacen que su rebaño sea rentable
Avance con su rebaño al ritmo más rápido
Controle el futuro genético de su rebaño con más novillas.
La genética superior para sementales Robot Ready™ es una ventaja para los productores lácteos automatizados.
Genética diseñada para desenvolverse en manejos pastoriles con la mejor adaptabilidad.
Sementales de alta fertilidad sin sacrificar la calidad.
Aumentando la rentabilidad de las lecherías con toros BeefUP
Cubriendo la demanda de sementales A2 homocigóticos.



